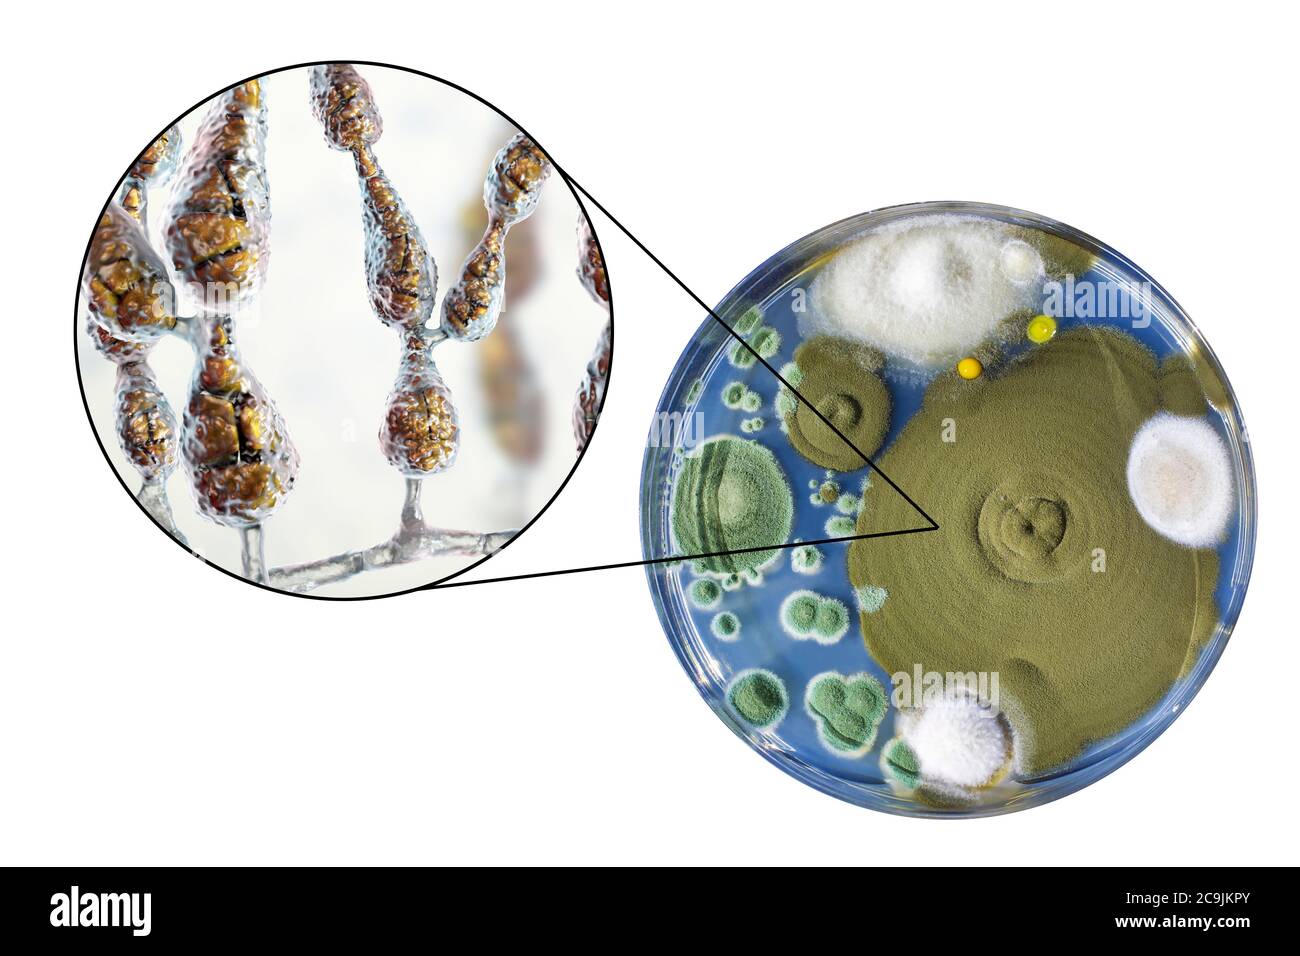
Champignon allergène filamenteux Alternaria alternata, illustration informatique de la morphologie fongique et photographie des colonies fongiques sur Sabouraud Dextrose Banque D'Images

Petri dish Banque d’images détourées
(8)Petri dish Banque d’images détourées
 Betterave germination dans une boîte de pétri sur un fond blanc. Banque D'Imageshttps://www.alamyimages.fr/image-license-details/?v=1https://www.alamyimages.fr/photo-image-betterave-germination-dans-une-boite-de-petri-sur-un-fond-blanc-166440761.html
Betterave germination dans une boîte de pétri sur un fond blanc. Banque D'Imageshttps://www.alamyimages.fr/image-license-details/?v=1https://www.alamyimages.fr/photo-image-betterave-germination-dans-une-boite-de-petri-sur-un-fond-blanc-166440761.htmlRFKJP0TW–Betterave germination dans une boîte de pétri sur un fond blanc.
 La germination des haricots dans des boîtes de Pétri sur un fond blanc. Banque D'Imageshttps://www.alamyimages.fr/image-license-details/?v=1https://www.alamyimages.fr/photo-image-la-germination-des-haricots-dans-des-boites-de-petri-sur-un-fond-blanc-166440698.html
La germination des haricots dans des boîtes de Pétri sur un fond blanc. Banque D'Imageshttps://www.alamyimages.fr/image-license-details/?v=1https://www.alamyimages.fr/photo-image-la-germination-des-haricots-dans-des-boites-de-petri-sur-un-fond-blanc-166440698.htmlRFKJP0PJ–La germination des haricots dans des boîtes de Pétri sur un fond blanc.
 Bay Tree (Laurus nobilis) Banque D'Imageshttps://www.alamyimages.fr/image-license-details/?v=1https://www.alamyimages.fr/bay-tree-laurus-nobilis-image65219650.html
Bay Tree (Laurus nobilis) Banque D'Imageshttps://www.alamyimages.fr/image-license-details/?v=1https://www.alamyimages.fr/bay-tree-laurus-nobilis-image65219650.htmlRFDP3096–Bay Tree (Laurus nobilis)
 Test de l'alimentation, conceptual image Banque D'Imageshttps://www.alamyimages.fr/image-license-details/?v=1https://www.alamyimages.fr/test-de-l-alimentation-conceptual-image-image65223888.html
Test de l'alimentation, conceptual image Banque D'Imageshttps://www.alamyimages.fr/image-license-details/?v=1https://www.alamyimages.fr/test-de-l-alimentation-conceptual-image-image65223888.htmlRFDP35MG–Test de l'alimentation, conceptual image
 La recherche pharmaceutique, conceptual image Banque D'Imageshttps://www.alamyimages.fr/image-license-details/?v=1https://www.alamyimages.fr/la-recherche-pharmaceutique-conceptual-image-image65223885.html
La recherche pharmaceutique, conceptual image Banque D'Imageshttps://www.alamyimages.fr/image-license-details/?v=1https://www.alamyimages.fr/la-recherche-pharmaceutique-conceptual-image-image65223885.htmlRFDP35MD–La recherche pharmaceutique, conceptual image
 La recherche pharmaceutique, conceptual image Banque D'Imageshttps://www.alamyimages.fr/image-license-details/?v=1https://www.alamyimages.fr/la-recherche-pharmaceutique-conceptual-image-image65223882.html
La recherche pharmaceutique, conceptual image Banque D'Imageshttps://www.alamyimages.fr/image-license-details/?v=1https://www.alamyimages.fr/la-recherche-pharmaceutique-conceptual-image-image65223882.htmlRFDP35MA–La recherche pharmaceutique, conceptual image
Champignon allergène filamenteux Alternaria alternata, illustration informatique de la morphologie fongique et photographie des colonies fongiques sur Sabouraud Dextrose Banque D'Imageshttps://www.alamyimages.fr/image-license-details/?v=1https://www.alamyimages.fr/champignon-allergene-filamenteux-alternaria-alternata-illustration-informatique-de-la-morphologie-fongique-et-photographie-des-colonies-fongiques-sur-sabouraud-dextrose-image367360307.html
Champignon allergène filamenteux Alternaria alternata, illustration informatique de la morphologie fongique et photographie des colonies fongiques sur Sabouraud Dextrose Banque D'Imageshttps://www.alamyimages.fr/image-license-details/?v=1https://www.alamyimages.fr/champignon-allergene-filamenteux-alternaria-alternata-illustration-informatique-de-la-morphologie-fongique-et-photographie-des-colonies-fongiques-sur-sabouraud-dextrose-image367360307.htmlRF2C9JKPY–Champignon allergène filamenteux Alternaria alternata, illustration informatique de la morphologie fongique et photographie des colonies fongiques sur Sabouraud Dextrose
 Champignon allergène filamenteux Alternaria alternata, illustration informatique de la morphologie fongique et photographie des colonies fongiques sur Sabouraud Dextrose Banque D'Imageshttps://www.alamyimages.fr/image-license-details/?v=1https://www.alamyimages.fr/champignon-allergene-filamenteux-alternaria-alternata-illustration-informatique-de-la-morphologie-fongique-et-photographie-des-colonies-fongiques-sur-sabouraud-dextrose-image367360289.html
Champignon allergène filamenteux Alternaria alternata, illustration informatique de la morphologie fongique et photographie des colonies fongiques sur Sabouraud Dextrose Banque D'Imageshttps://www.alamyimages.fr/image-license-details/?v=1https://www.alamyimages.fr/champignon-allergene-filamenteux-alternaria-alternata-illustration-informatique-de-la-morphologie-fongique-et-photographie-des-colonies-fongiques-sur-sabouraud-dextrose-image367360289.htmlRF2C9JKP9–Champignon allergène filamenteux Alternaria alternata, illustration informatique de la morphologie fongique et photographie des colonies fongiques sur Sabouraud Dextrose